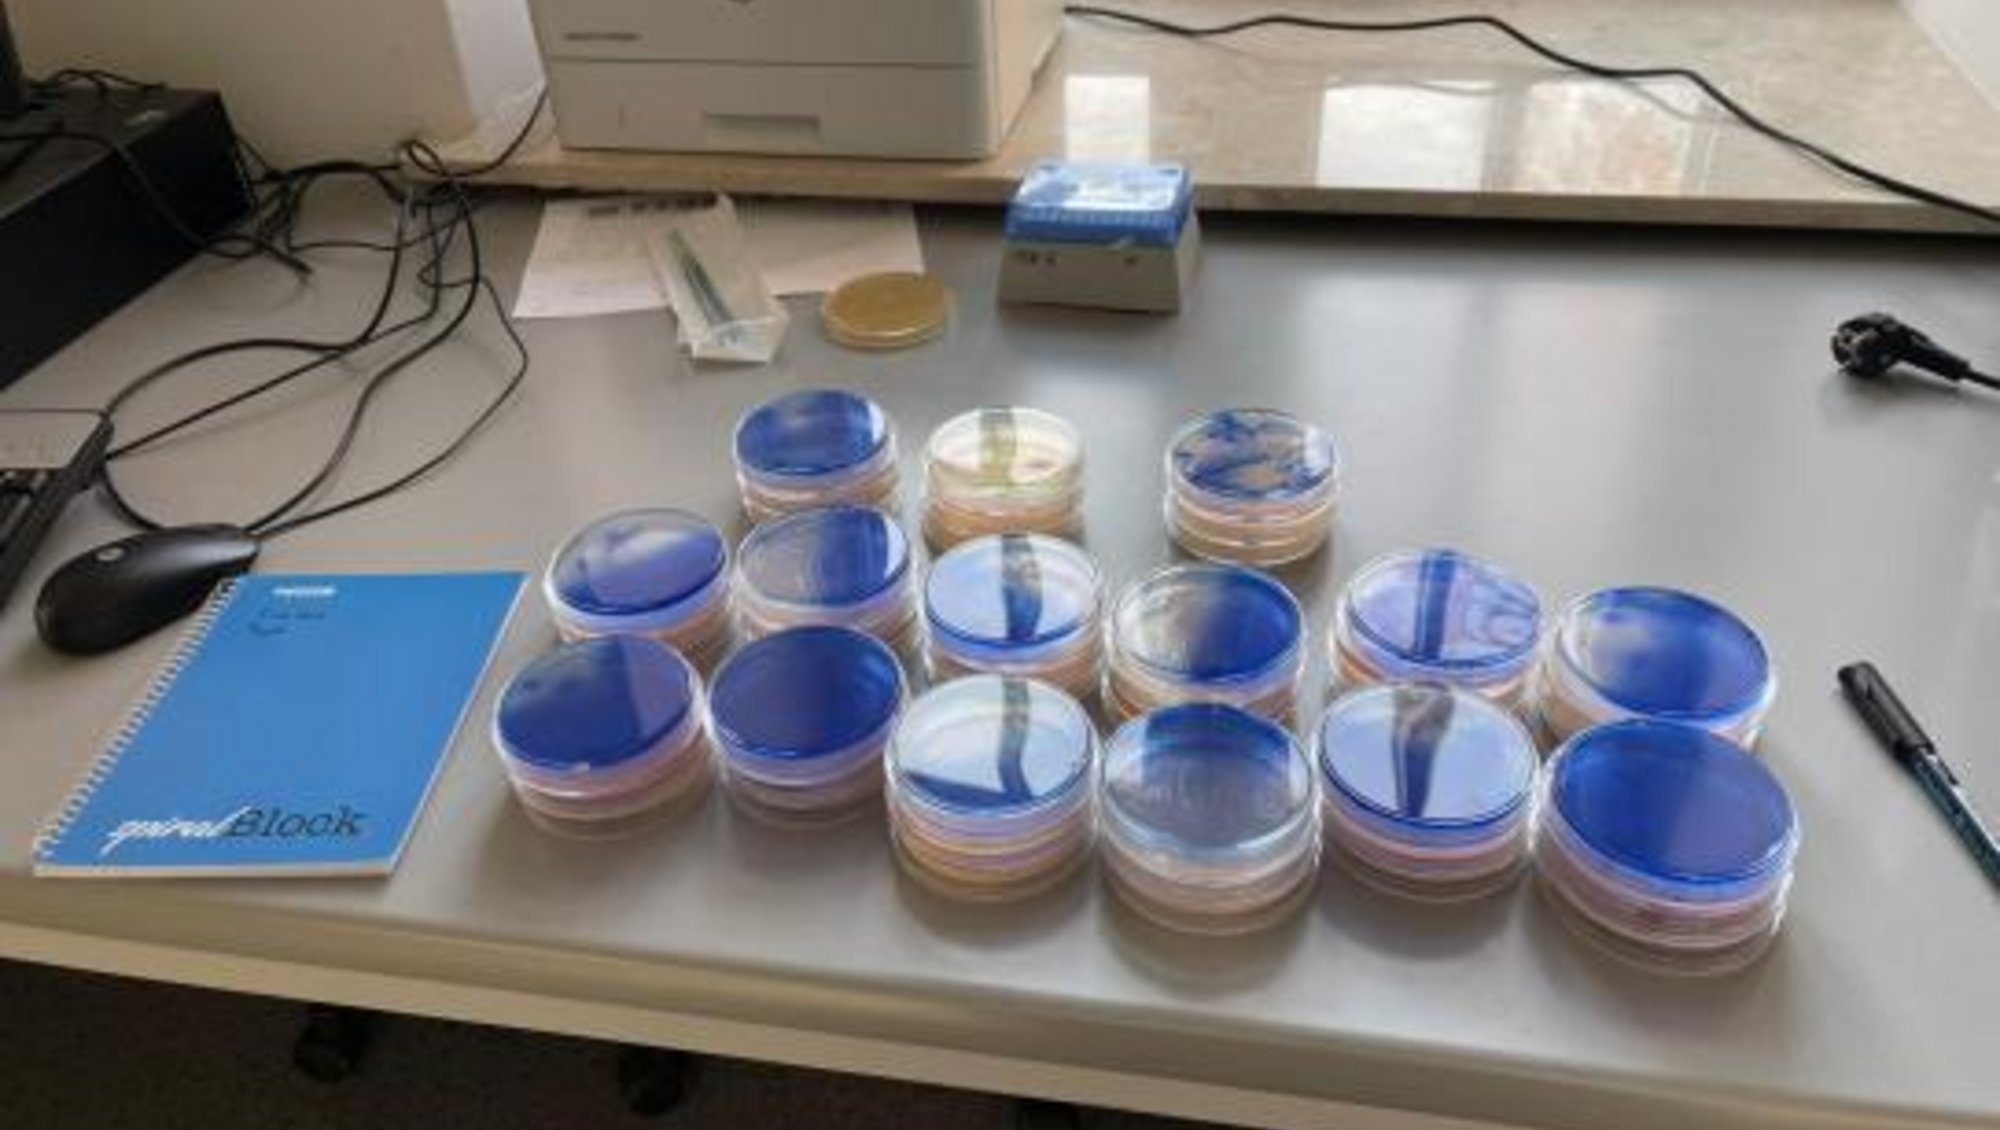

Chiara Pisana
Research Area:
🌿Microbiology 🌿Molecular Biology 🌿Food Technology
"I have a strong passion for food and nutrition in all its aspects, with a particular interest in food microbiology. I’m especially drawn to exploring how microbial systems can be harnessed to improve food safety, promote sustainability, and support healthier, more natural food production," Chiara Pisana.
About the mobility grant visit
Hosting Institution: Department of Food Microbiology, Meat Technology and Chemistry, University of Warmia and Mazury in Olsztyn, Olsztyn, Poland
From October 2025 to December 2025
Proposed Project during Mobility visit:
Sustainable and innovative biocontrol systems to improve fresh cheeses safety through bacteriophages and postbiotics.
The idea behind this project is to make food safer and free from chemical preservatives.
By offering a natural alternative to synthetic preservatives and plastic, we can help reduce waste, support organic food production, and move towards a more circular and sustainable food system.
Highlights from the stay
"Working intensively on strain selection has improved my ability to interpret results in a comparative and systematic manner, which is essential for identifying robust and reproducible biocontrol candidates. At the same time, the ongoing qPCR work has enhanced my familiarity with molecular
techniques and data interpretation in the context of food microbiology.The continuous interaction with my supervisor played a key role in supporting my scientific reasoning and in guiding decision-making throughout the experimental process. Overall, December represented an important phase of consolidation and progress, contributing significantly to both my scientific development and the advancement of the core objectives of the mobility project," Chiara Pisana.

Chiara Pisana
PhD Candidate
Department of Agricolture Food and Environment, University of Catania, Italy
Academic Background (BA and MA degrees):
BA degree Biological Sciences, University of Siena, 2020
MA degree Biology, University of Perugia, 2024